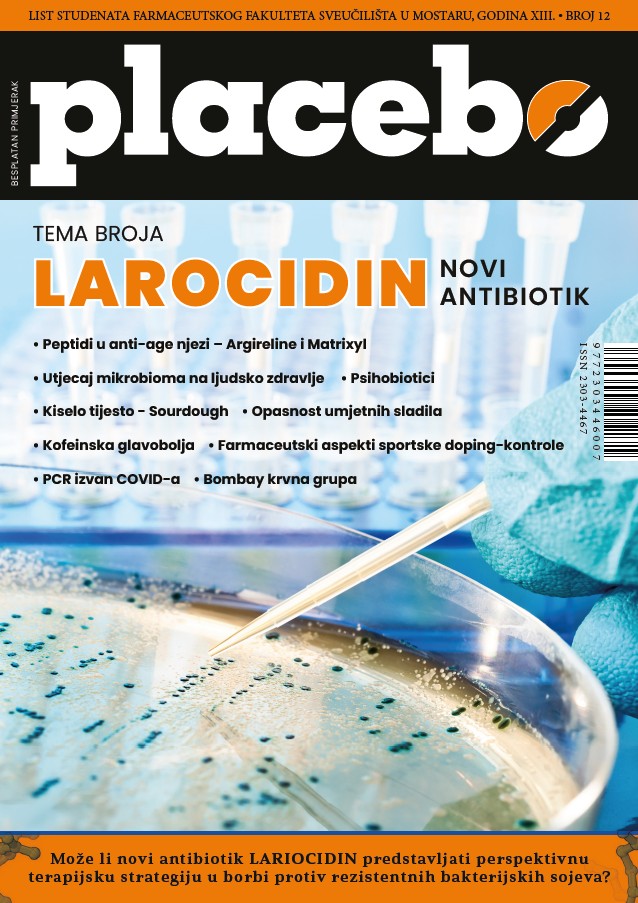

Novi broj studentskog lista Placebo
Novi broj studentskog lista Placebo možete pročitati klikom na sliku:
Ostale brojeve lista Placebo možete pregledati na slijedećem linku:
Placebo studentski list